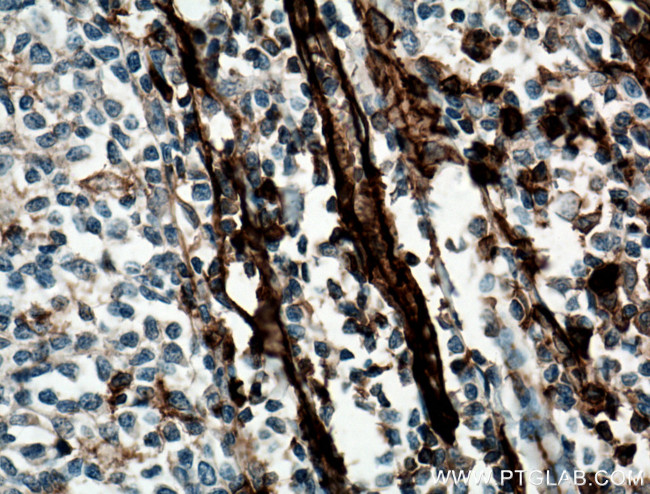
CD31 Antibody in Immunohistochemistry (Paraffin) (IHC (P))

Search
Proteintech
CD31 Polyclonal Antibody
{{$productOrderCtrl.translations['antibody.pdp.commerceCard.promotion.promotions']}}
{{$productOrderCtrl.translations['antibody.pdp.commerceCard.promotion.viewpromo']}}
{{$productOrderCtrl.translations['antibody.pdp.commerceCard.promotion.promocode']}}: {{promo.promoCode}} {{promo.promoTitle}} {{promo.promoDescription}}. {{$productOrderCtrl.translations['antibody.pdp.commerceCard.promotion.learnmore']}}
产品信息
11265-1-AP
种属反应
已发表种属
宿主/亚型
分类
类型
抗原
偶联物
形式
浓度
规格
纯化类型
保存液
内含物
保存条件
运输条件
产品详细信息
Immunogen sequence: EVRCESISG TLPISYQLLK TSKVLENSTK NSNDPAVFKD NPTEDVEYQC VADNCHSHAK MLSEVLRVKV IAPVDEVQIS ILSSKVVESG EDIVLQCAVN EGSGPITYKF YREKEGKPFY QMTSNATQAF WTKQKANKEQ EGEYYCTAFN RANHASSVPR SKILTVRVIL APWKKGLIAV VIIGVIIALL IIAAKCYFLR KAKAKQMPVE MSRPAVPLLN SNNEKMSDPN MEANSHYGHN DDVGNHAMKP INDNKEPLNS DVQYTEVQVS SAESHKDLGK KDTETVYSEV RKAVPDAVES RYSRTEGSLD GT (428-738 aa encoded by BC022512)
靶标信息
CD31 (platelet endothelial cell adhesion molecule-1, PECAM-1) is an inhibitory coreceptor involved in regulation of T cell and B cell signaling by a dual immunoreceptor tyrosine-based inhibitory motif (ITIM) that upon associated kinases-mediated phosphorylation provide docking sites for protein-tyrosine phosphatases. CD31 is expressed ubiquitously within the vascular compartment and is located mainly at junctions between adjacent cells. N-terminal Ig-like domain of CD31 is responsible for its homophilic binding, which plays an important role in cell-cell interactions. CD31 is a multifunctional molecule with diverse roles in modulation of integrin-mediated cell adhesion, transendothelial migration, angiogenesis, apoptosis, negative regulation of immunoreceptor signaling, autoimmunity, macrophage phagocytosis, IgE-mediated anaphylaxis and thrombosis. It is one of key regulatory molecules in vascular system.
仅用于科研。不用于诊断过程。未经明确授权不得转售。
生物信息学
蛋白别名: adhesion molecule; CD31; CD31 antigen; EndoCAM; GPIIA'; PECA1; PECAM-1; PECAM-1 precursor; Platelet endothelial cell adhesion molecule; platelet endothelial cell adhesion molecule-1; unnamed protein product
基因别名: CD31; CD31/EndoCAM; endoCAM; GPIIA'; PECA1; PECAM-1; PECAM1
UniProt ID: (Human) P16284
Entrez Gene ID: (Human) 5175